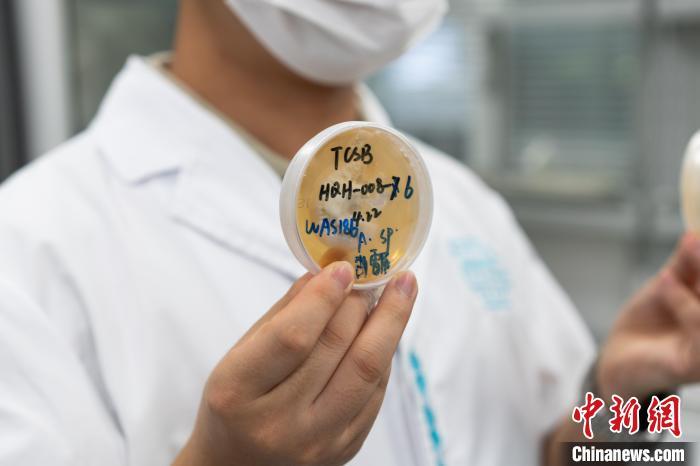

">
中新社重慶8月25日電 題:為館藏文物“尋菌捉蟲” 重慶科研團隊出“妙招”
中新社記者 鐘旖
書畫、漆器、皮革類、紡織品等有機質文物易受保存環境中的光線、溫度、濕度等物理因素影響,因害蟲和微生物導致文物的生物劣化,也常困擾文物保護工作者。
中新社記者25日從重慶中國三峽博物館獲悉,該館科研團隊開展的“館藏文物蟲霉病害防治研究”項目正為業內文物蟲霉病害防治提供創新方案,多項研究系“中國唯一”,相關成果已服務全國50余家文博單位。
“這是一項積累了30多年探索的研究?!敝貞c中國三峽博物館文物保護與考古部副主任唐歡介紹,重慶既是“霧都”又是“火爐”,濕熱環境使文物很容易長霉、生蟲。從20世紀90年代起,該館文保工作者就向蟲霉病害發起“挑戰”,為館藏文物生物病害防治科學研究奠定了堅實基礎。
重慶中國三峽博物館文物保護與考古部工作人員展示從文物上采集的霉變樣本。中新社記者 鐘旖 攝
面對業內文物蟲霉病害防治專業人員匱乏的問題,重慶中國三峽博物館還組建了一支“既懂生物又懂文物”的復合型研究隊伍,半數以上的“90后”青年來自理工農醫等多個學科。
“我是學習農藥學的,沒想到所學能應用于文保領域?!碑厴I于西南大學的劉家路博士稱,其最大的變化是把研究蟲的工作從農田搬至博物館。霉變主要由真菌引起,而蟲害是文物本體及其環境中存在的蟲源直接導致的,為摸清蟲霉病害的“家底”,入職三年多,他和團隊已到中國60余家文博機構“尋菌捉蟲”。
基于來自全國各地的蟲霉病害數據資源,重慶中國三峽博物館成功建立中國唯一的館藏文物生物病害致病菌種庫和蟲種庫,涵蓋真菌182種、害蟲8種、病害圖片8000余張,為蟲霉病害消殺效果評估提供指示菌和指示蟲。結合卷積神經網絡算法,團隊還搭建了中國首個文物常見生物病害在線專家系統。通過圖片和序列上傳比對,實現館藏文物生物病害快速識別,極大提升了缺乏生物背景知識的基層文物保管人員對文物蟲霉病害風險的感知和管理能力。

重慶中國三峽博物館文物保護與考古部工作人員展示采集到的蟲種。中新社記者 鐘旖 攝
記者了解到,文物霉變和蟲蛀一旦被肉眼發現時,往往已經十分嚴重,為后續的保護修復帶來極大困難。生物化學與分子生物學專業博士覃丹介紹,除了館藏文物生物劣化機制研究、數據庫建設,團隊近年來還通過研發植物源熏蒸劑與裝備,實現館藏文物生物病害防治技術的原創性突破。
“植物精油因其天然的抗蟲和抗霉特性,常被用于農業、日化、醫藥等領域,這啟發了我們。”覃丹說,團隊通過查閱文獻,篩選出上百種可能對文物蟲霉病害防治有效的植物提取精油,在反復測試和優化后,成功調配出10余種高效、安全并適用于環境消殺的植物源熏蒸劑配方。此外,團隊原創設計的最新版本熏蒸器內設傳感器,能自動感應環境溫度和濕度,當溫度和濕度超過一定閾值時,熏蒸器會自動啟動,確保文物保存環境的適宜。
“目前,團隊科研成果輻射范圍涵蓋濕熱多雨、霉蟲高發的南方地區以及寒冷干燥的西北地區,極大地拓寬了研究成果的應用場景和適用區域?!碧茪g表示,從微觀到宏觀,從基礎理論到應用實踐,雖然“館藏文物蟲霉病害防治研究”的維度眾多,但文保工作者“服務文物保護需求”的初心不會改變。(完)
Copyright ? 2001-2025 湖北荊楚網絡科技股份有限公司 All Rights Reserved
互聯網新聞信息許可證 4212025003 -
增值電信業務經營許可證 鄂B2-20231273 -
廣播電視節目制作經營許可證(鄂)字第00011號
信息網絡傳播視聽節目許可證 1706144 -
互聯網出版許可證 (鄂)字3號 -
營業執照
鄂ICP備 13000573號-1
鄂公網安備 42010602000206號
版權為 荊楚網 www.cnhubei.com 所有 未經同意不得復制或鏡像